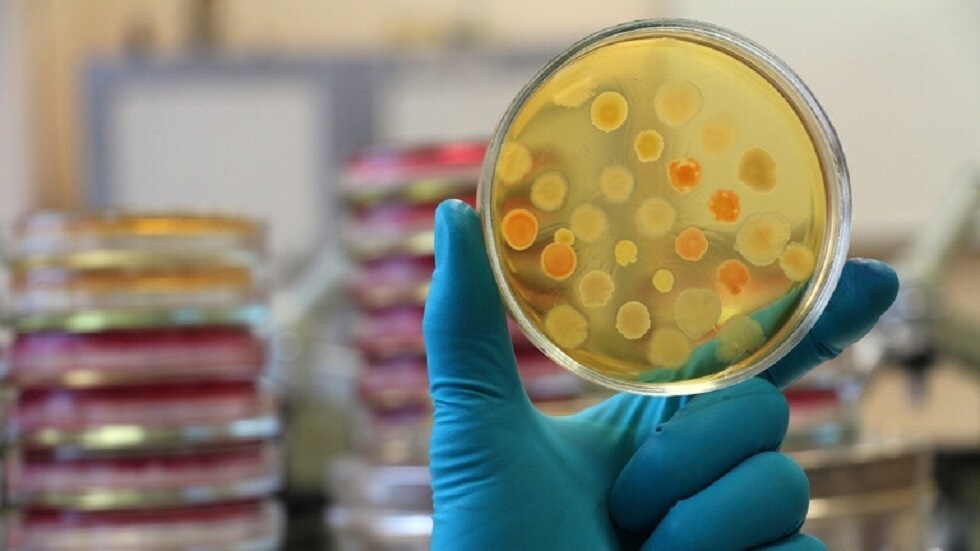

آخر الأخبار
- البنتاغون يحدد هويات 4 جنود قُتلوا في حرب إيران
- تقرير يكشف خفايا العملية التي أنهت حياة خامنئي
- واشنطن تراهن على فراغ مخازن طهران.. وتضغط على شركات السلاح
- جدل إيقاف رياضيين إسرائيليين وأمريكيين… واللجنة الأولمبية ترد
- الحرب على إيران.. واشنطن تسيطر على أجواء إيران والحرس الثوري يعلن خسائر أمريكية
- "قاتل آية الله".. أوجه مأزق ترامب في إيران والضحية التالية!
- قصف إسرائيلي يستهدف فندقا شرق بيروت ومبنى سكنيا في بعلبك
- إيران بين "التفكيك" و"حرب الاستنزاف".. قراءة في سيناريوهات المواجهة
- تغيير النظام أم تغيير السلوك؟.. هذا ما تريده واشنطن بإيران وفنزويلا وكوبا
- قائد سنتكوم: 50 ألف جندي يشاركون في العمليات ونهيمن بالكامل على أجواء إيران
- واشنطن ترفع مستوى التحذير من السفر إلى الأردن وعُمان والسعودية والإمارات إلى المستوى الثالث
- موجة قصف واسعة تضرب إيران وصواريخ على قلب إسرائيل
- غرق ناقلة غاز روسية قبالة السواحل الليبية
- ترمب يدافع عن حرب إيران أمام انتقادات تاكر كارلسون ومحافظين آخرين
- حزب الله يعلن استهداف قاعدة حيفا البحرية
- غارات إسرائيلية دامية على لبنان وإنذارات بإخلاء 16 بلدة جنوبية
- إسرائيل تعيد فتح مجالها الجوي تدريجيا بدءا من ليل الأربعاء
- انفجارات عنيفة تهز وسط إسرائيل وصواريخ إيرانية تضرب القدس والنقب
روسيا.. فريق أحمد يصعق تسيسكا موسكو بهدف سريع (فيديو)
شارك
في حال واجهت مشكلة في مشاهدة الفيديو، إضغط على رابط المصدر للمشاهدة على الموقع الرسمي
حقق فريق أحمد غروزني فوزا ثمينا على ضيفه تسيسكا موسكو بهدف وحيد في المباراة التي جمعتهما مساء اليوم الأحد، ضمن منافسات الجولة التاسعة عشرة من الدوري الروسي الممتاز لكرة القدم.
الصورة من الجولة العاشرة بين تسيسكا موسكو وأحمد / Александр Вильф / Sputnik
ويدين أصحاب الأرض بالفضل في هذا الانتصار للمهاجم الكازاخي مكسيم سامورودوف الذي أحرز هدف الفوز الوحيد لهم مبكرا بعد مرور أربع دقائق فقط من انطلاق صفارة البداية.
وتوقف رصيد فريق تسيسكا موسكو بعد هذه الهزيمة عند 36 نقطة، ويحتل المركز الرابع في جدول ترتيب الدوري.
في حين رفع نادي أحمد غروزني رصيده إلى 22 نقطة، ويشغل المركز التاسع على سلم الترتيب.
المصدر: RT
 المصدر:
روسيا اليوم
المصدر:
روسيا اليوم
شارك